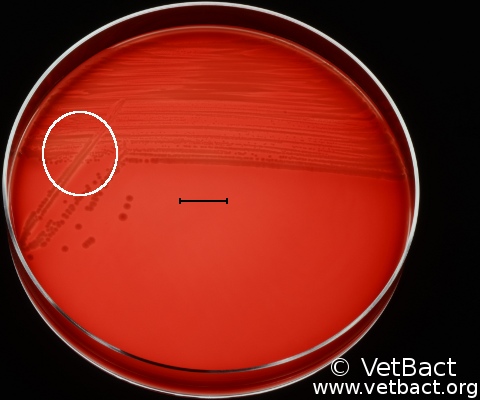
<i>Bordetella bronchiseptica</i>

Bordetella bronchiseptica
Fig. 53:2. Colonies of Bordetella bronchiseptica, strain xxx, cultivated on bovine blood agar at 37°C during 48 h. Lighting from below during photography. Note that a weak hemolysis can be observed within the encircled area of the plate. The length of the scale bar corresponds to 10 mm.
Credit: Karl-Erik Johansson (BVF, SLU) & Lise-Lotte Fernström (BVF, SLU).

This work is licensed under a Creative Commons Attribution 2.5 Sweden License.